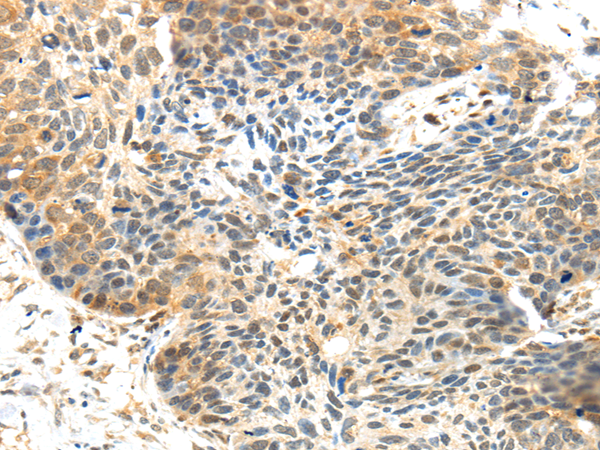

中文名稱: 兔抗MET多克隆抗體
英文名稱: Anti-MET rabbit polyclonal antibody
別 名: HGFR; AUTS9; RCCP2; c-Met
相關(guān)類別: 一抗
儲 存: 冷凍(-20℃)
宿 主: Rabbit
抗 原: MET
反應(yīng)種屬: Human, Mouse, Rat
標(biāo) 記 物: Unconjugate
克隆類型: rabbit polyclonal
技術(shù)規(guī)格
|
Background: |
The proto-oncogene MET product is the hepatocyte growth factor receptor and encodes tyrosine-kinase activity. The primary single chain precursor protein is post-translationally cleaved to produce the alpha and beta subunits, which are disulfide linked to form the mature receptor. Various mutations in the MET gene are associated with papillary renal carcinoma. Two transcript variants encoding different isoforms have been found for this gene. |
|
Applications: |
ELISA, WB, IHC |
|
Name of antibody: |
MET |
|
Immunogen: |
Synthetic peptide of human MET |
|
Full name: |
MET proto-oncogene, receptor tyrosine kinase |
|
Synonyms: |
HGFR; AUTS9; RCCP2; c-Met; DFNB97 |
|
SwissProt: |
P08581 |
|
IHC positive control: |
Human esophagus cancer |
|
IHC Recommend dilution: |
25-100 |
|
WB Predicted band size: |
156 kDa |
|
WB Positive control: |
Hela and A431 cell lysates |
|
WB Recommended dilution: |
500-2000 |

購物車
幫助
021-54845833/15800441009
